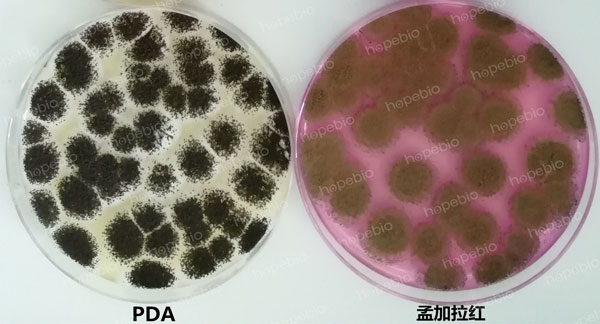
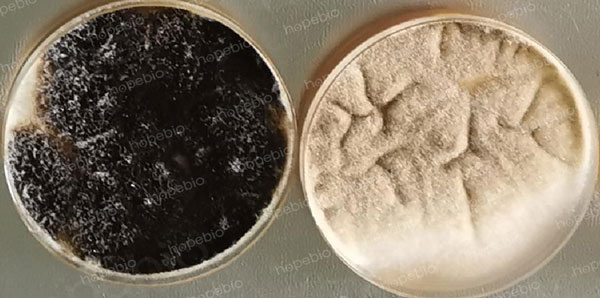
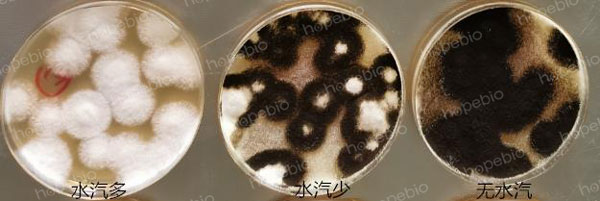

海博微信公众号
海博微信公众号
 海博天猫旗舰店
海博天猫旗舰店


 海博微信公众号
海博微信公众号
 海博天猫旗舰店
海博天猫旗舰店




一、简介
霉菌是一些丝状真菌的统称,不是分类学的名词。霉菌在生活中无处不在,喜欢温暖潮湿的环境,在合适的环境中会大量地繁殖。霉菌有的会使食品转变为有毒物质,有的可能在食品中产生毒素,即霉菌毒素,对人体健康造成的危害极大,主要表现为慢性中毒、致癌、致畸、致突变作用。自发现黄曲霉毒素以来,霉菌与霉菌毒素对食品的污染日益引起重视。
食品、药品、化妆品、饲料和进出口相关产品的检验中,均有明确的霉菌计数标准。同时,对于一些洁净环境的监测,对霉菌的数量也有严格要求。
二、标准与产品
为了更好地检出特定产品中的霉菌,不同的标准所使用的培养基有所差别。
(1)《GB4789.15-2016 食品安全国家标准 食品微生物学检验 霉菌和酵母计数》中推荐使用的培养基是马铃薯葡萄糖琼脂(HB0233)或孟加拉红琼脂(HB0237-2)。

霉菌在这两种培养基上的生长状态如下(图1):
图1 黑曲霉在PDA和孟加拉红培养基上的生长状态
(2)《GB/T 13029-2006 饲料中霉菌总数的测定》中,霉菌计数采用高盐察氏培养基。

霉菌在其上面的生长状态如下(图2):

图2 霉菌在高盐察氏琼脂上的生长特征
(3)《SN/T 5090.1-2018 中华人民共和国出入境检验检疫行业标准 商品化试剂盒检测方法 霉菌和酵母菌方法》中,推荐使用PYM测试片,且明确描述了霉菌的形态:颜色多样,中心颜色深暗的大型或小型扁平扩散菌落。

(4)《中国药典》则选用沙氏葡萄糖琼脂(SDA HB0253-81)作为霉菌计数的培养基

三、计数操作
有关霉菌的计数,一般要求从第3天开始观察计数,持续至第5天或1周,有些霉菌长得很快,且如果样品中菌数又比较多的话,第3天可能就无法有效分辨了,所以需要从第2天就持续观察,只要肉眼可见菌丝团就标记为一个菌落。在检验过程中要根据具体情况进行观察结果,不能接种完毕,一直等到最后的期限再去计数。这样就可能面临平板上所有的真菌都连成一片的情况,造成计数结果不准确或无法计数。
另外,还应该注意,培养基的质量不同、培养条件的差别,都会导致霉菌产孢子能力有差异(如图3、图4),不能只靠有无孢子来判断是不是霉菌,通常来说,只要有肉眼可见的菌丝,即使暂时没有看到明显的孢子,也应该算作霉菌进行计数。
图3 黑曲霉在两种不同品牌的同种培养基上培养相同时间的产孢子情况
(左侧为海博的SDA)
图4 黑曲霉同时接种在同种培养基(SDA)上,因盖子上水汽多少造成的产孢子情况差异
相关产品:
相关标准:
《GB 4789.15-2016 食品安全国家标准 食品微生物学检验 霉菌和酵母计数》-点击查看详情
上一篇:支原体采样管使用说明
下一篇:创伤弧菌介绍
| 相关文章: | ||



